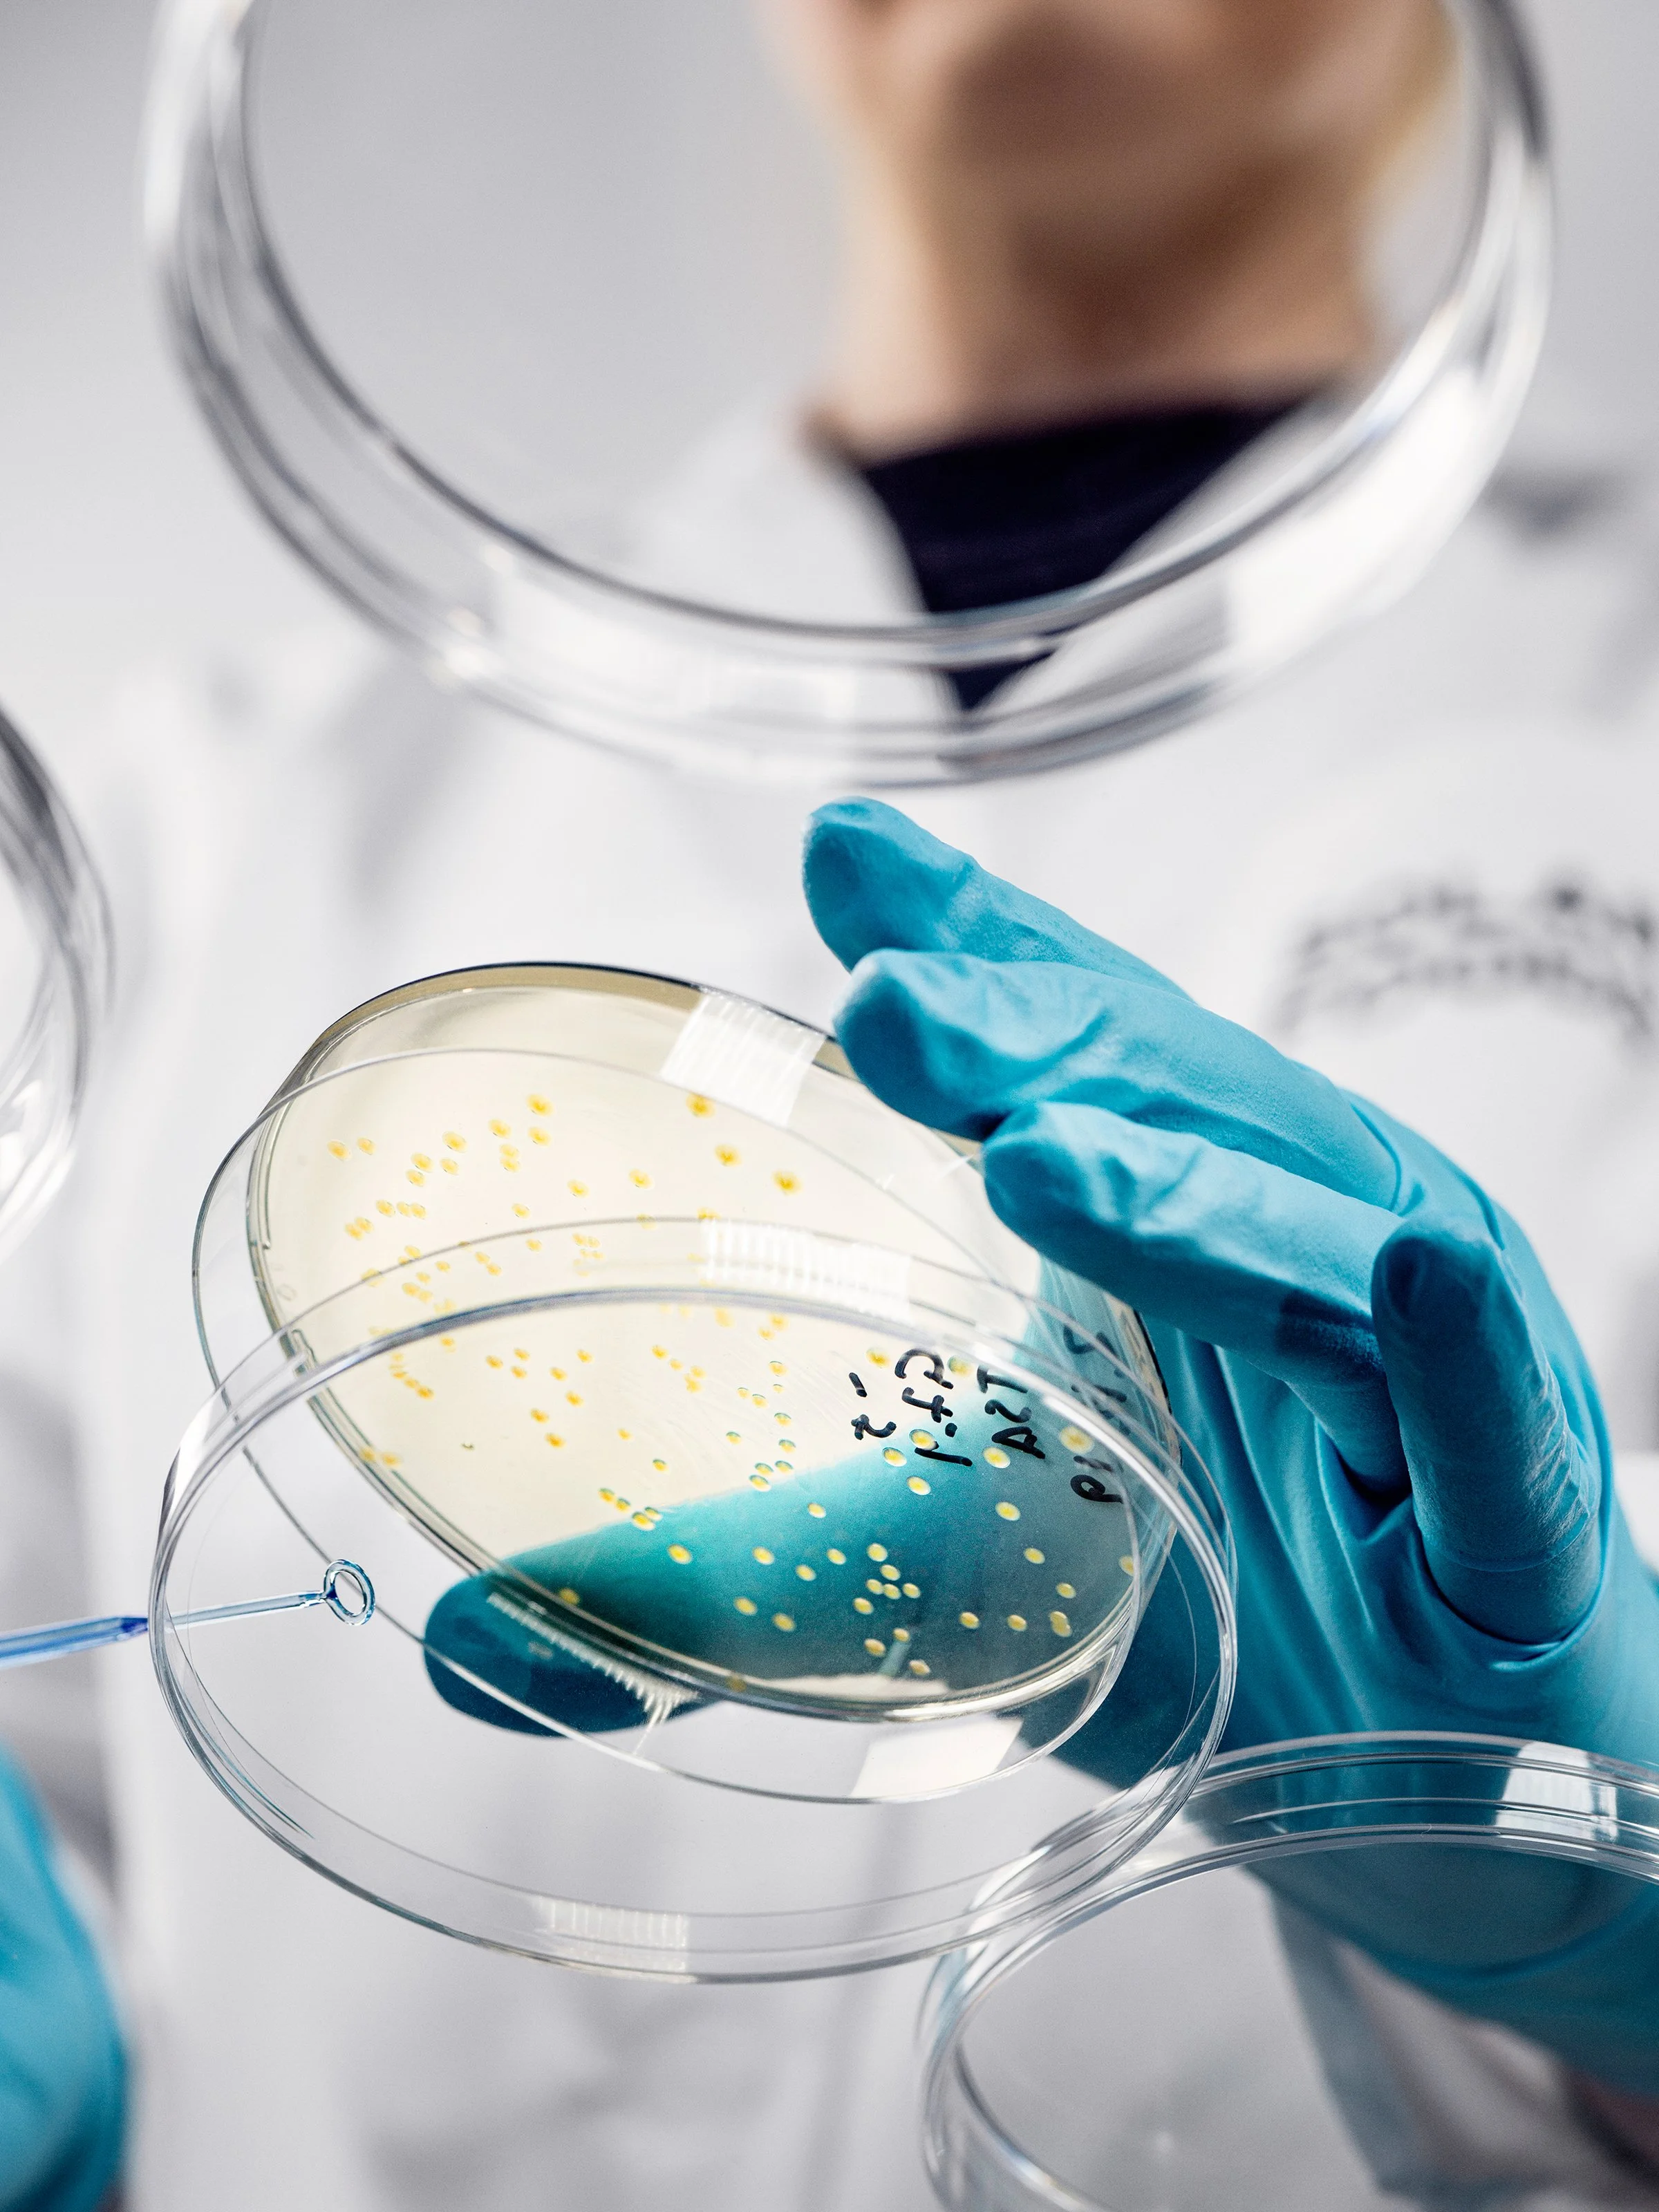

Proteiinia ilmasta: Juha-Pekka Pitkänen ja Solar Foods haastavat lehmät ja kasvimaat ruuantuottajana
Ruoka ei ole enää vain ruokaa. Se on eettinen ja moraalinen valinta, joka vaikuttaa omaan hyvinvointiin, ilmastoon, eläimiin, yhteiskuntaan, politiikkaan ja niin edelleen. Vanha ruoantuotannon malli natisee liitoksissaan. Omavaraisuus ja huoltovarmuus huolettaa monia. Samaan aikaan proteiinin kysyntä kasvaa nopeammin kuin viljelyalat tai lehmien määrä. KRONIKAT
Ruokapöytiimme nousee koko ajan uusia vaihtoehtoja: kasvipohjaisia tuotteita ja bioteknisiä keksintöjä. Yksi villeimmistä ideoista on tehdä proteiinia ilmasta. Prosessia on tutkittu VTT:n ja LUT-yliopiston yhteistyönä, ja pian keksinnön kaupallinen tuotanto isossa mittakaavassa voi toteutua Lappeenrannassa.
Uutta tuotantolaitosta suunnittelee Solar Foods. Yritys, joka tuottaa hiilidioksidista sähköenergian avulla mikrobimassaa, jota voidaan hyödyntää ravintoproteiinina. Soleiniksi kutsuttu proteiinijauhe ei ole itsenäinen tuote, vaan raaka-aine elintarviketeollisuudelle. Singaporessa myydään jo soleini-jäätelöä vegaaneille. Laajempi maailmanvalloitus on vielä suunnitteluasteella: Lappeenrannan tuotantolaitokselle on varattu tontti, mutta valtion tuki on vielä epävarmaa.
Solar Foodsin prosessissa ravintoa voidaan tehdä sähköstä, vedystä ja hiilidioksidista. Proteiinin tuottamiseen ei siis tarvita peltoja, eläimiä tai edes auringonvaloa. Kysymys ei ole enää siitä, onko se mahdollista – vaan siitä, olemmeko me siihen valmiita? SOLAR FOODS
NASA:n unelma herää henkiin
Solar Foodsin teknologia kuulostaa science fictionilta, mutta periaate on yllättävän yksinkertainen, ja idea on vanha. NASA investoi 1960-luvulla tämän tyyppiseen tutkimukseen. Ajatus oli, että pitkillä avaruusmatkoilla olisi mahdollista tuottaa helposti ravintoa astronauteille. Kun avaruusaluksessa tehdään elektrolyysillä happea miehistölle, syntyy sen sivutuotteena vetyä. Hiilidioksidia taas syntyy automaattisesti ihmisistä. Oli ajatus kasvattaa mikrobeja ruoaksi bioreaktorissa näiden aineiden avulla.
– Olemme elvyttäneet tämän vanhan ajatuksen ja vieneet sitä eteenpäin, Solar Foodsin tieteellinen johtaja Juha-Pekka Pitkänen kertoo.
Solar Foodsin prosessi toimii näin: vesi hajotetaan sähkövirran avulla vedyksi ja hapeksi, ja ilmasta otetaan talteen hiilidioksidia. Bioreaktorissa olevaa mikrobia ruokitaan hapella, vedyllä ja hiilidioksidilla sekä mineraaleilla ja ammoniakilla – vähän kuin kasvatettaisiin leivinhiivaa tai maitohappobakteeria jogurttiin.
– Ero leivinhiivan kasvatukseen on siinä, että kun hiiva käyttää sokeria, niin meidän organismimme käyttää vetyä. Olennaista tässä on irtikytkentä maataloudesta. Emme tarvitse kasveja tähän ollenkaan, Pitkänen selittää.
Valmiissa mikrobijauheessa on proteiinia 75 prosenttia. Lopputulos on vähän kuin Quorn-sieniproteiini tai Spirulina-mikrolevä – se on kuollutta biomassaa, jota voidaan käyttää elintarvikkeena. SOLAR FOODS
Taustalla bioetanoli-kokeilut
Solar Foodsin tarina juontaa vuoteen 2017, jolloin kaksi VTT:n tutkijaa – Pitkänen ja Pasi Vainikka – päättivät perustaa yrityksen, joka tuottaisi proteiinia mikrobeilla. Taustalla oli vuosien tutkimustyö ja kokemusta start upeista.
Pitkänen väitteli Teknillisestä korkeakoulusta vuonna 2005 bioprosessitekniikkaan ja hiiva-aineenvaihduntaan erikoistuneena tutkijana. Vuodesta 2012 lähtien VTT:llä ryhdyttiin tutkimaan muita mikrobeja ja bakteereja kuin hiivaa. Pitkänen ja hänen energiatekniikkaan perehtynyt kollegansa testasivat laboratoriomittakaavassa teknologian toimivuutta – ja päätyivät rohkeaan johtopäätökseen.
– Kylmän insinöörilaskennan perusteella päädyimme siihen, että jos teemme ilmasta ruokaa, niin se voi olla kannattavaa. Ja tällä polulla ollaan yhä, myhäilee Pitkänen.
Muun tiimin muodostuminen tapahtui luontevasti. Pitkänen ja Vainikka pyysivät VTT:ltä mukaansa Sami Holmströmin. Alkuperäiseen tiimiin kuuluu myös kolme advisor-jäsentä: professori Jero Ahola Lappeenrannan yliopistosta, jolla on uusiutuvan energian taustaa sekä liiketoiminnan advisorit Jari Tuovinen ja Janne Mäkelä.
– Kun itse tulee tutkijataustalla, niin tarvitsee apuja bisnesmaailman kanssa. Olemme saaneet advisoreilta apuja arvonmuodostukseen, rahoituksen hakemiseen ja sopimusten tekoon. (Juha-Pekka Pitkänen) SOLAR FOODS
Kahdeksan vuotta perustamisensa jälkeen Solar Foods on yhä tappiollinen. Yhtiö on kerännyt kymmeniä miljoonia investointirahaa, ja nyt kaupallinen tuotanto on liipaisimella. Tällä hetkellä kehityksessä on kolme päälinjaa: täyden kaupallisen mittakaavan tuotantolaitoksen suunnittelu, tuotteen ison luokan kaupallistaminen sekä lupaprosessit eri maissa.
– Kannattavuus liiketoiminnassa on kuin huiputtaminen vuorikiipeilyssä. Mitä lähemmäksi huippua pääset, sitä vaikeammaksi se myös muuttuu. Perusleiriin pääsen moni, huipulle harvempi, kuvailee yrittäjä.
Yle uutisoi joulun alla, että Solar Foods suunnittelee kasvattavansa soleinin tuotantokapasiteettinsa Lappeenrannan Selkäharjuun kaavaillulla tehtaalla nykyisestä 160 tonnista 6 400 tonniin vuodessa. Moni voi epäillä, onko laboratoriossa kehitetty teknologia mahdollista skaalata näihin volyymeihin ja vielä taloudellisesti kannattavasti? Ja ottavatko kuluttajat tämän vaihtoehdon käyttöönsä? Pitkänen kokee, että hänellä on velvollisuus kokeilla.
– Olen kuitenkin saanut ilmaisen koulutuksen korkeimpaan tasoon, mitä Suomessa voi saada, tohtorikoulutuksen. Olen myös tehnyt käytännössä puolet urastani julkisella sektorilla ja puolet start upeissa. Koen, että minulla on velvollisuus viedä tutkimuslaitoksessa syntyneet ideat kaupalliseksi toiminnaksi. Sitä vartenhan meidät on koulutettu ja tutkimusta tehty, että ne ideat ja aihiot sitten viedään kaupalliseen mittakaavaan, muistuttaa tutkija.
Pitkäsen mukaan Solar Foods on yritys, jossa hänellä on koko osaaminen ja kokemus parhaiten käytössä.
Energiatehokkuus ja energiatehokas ravinnontuotanto on keskeinen mittari Solar Foodsille. Fotosynteesi, jossa kasvit muuttavat auringonvaloa energiaksi, toimii alle prosentin tehokkuudella. Pitkäsen mukaan heidän prosessinsa on yli kymmenen kertaa tehokkaampi. SOLAR FOODS
– Mikrobille riittää yksinkertaisemmat raaka-aineet ja olosuhteet kuin kasveille ja lehmälle yhdessä.
Auringonvaloa ei tarvita suoraan ollenkaan, prosessi toimii pimeässä vuorokauden ympäri ja vuoden ympäri. Tarvitaan vain sähköä ja alkuaineita. Pitkäsen mukaan soleinin aineksista 95 prosenttia tulee ilmasta ja vedestä, mikä tekee siitä uusiutuvan ja ekologisen.
Nyt ehkä herää kysymys: jos prosessi on näin tehokas, miksi luonto ei ole keksinyt sitä? Ja toisaalta: meneekö jotain rikki, jos luonnon ravinnontuotantoa kiihdytetään näin? Onko buustattu proteiini turvallista syöjälle?
Dystopia vai pelastus?
Turvallisuuskysymys ei olekaan yksinkertainen. Pitkänen kertoo, että kaikki turvallisuuskokeet on tehty. Allergiatestit ovat menossa, mutta kliinisiä tutkimuksia tai pitkäaikaistutkimuksia ei ole tehty.
– Tähän mennessä ei ole tullut ilmi mitään ongelmia. Mutta tieteentekijänä ei voi ikinä mitään sulkea pois, Pitkänen toteaa rehellisesti. SOLAR FOODS
Tässä piilee teknologisen optimismin ja varovaisuuden välinen jännite. Solar Foods on saanut myyntiluvan Singaporessa vuonna 2021, Yhdysvalloissa yhtiöllä on GRAS-status (Generally Recognized As Safe). EU:n sekä Britannian hyväksyntää odotetaan – mahdollisesti jo vuonna 2026.
Kriitikko voisi sanoa, että Solar Foods edustaa ruoantuotannon teollistumisen äärimmäistä muotoa: proteiinia tuotetaan teräsastioissa, prosessi on täysin irti luonnosta, ja lopputulos on standardoitu, optimoitu biomassa. Pitkänen muistuttaa, että vaikka soleinin tuotanto kasvaisi kuinka isoksi, ei se voi koskaan korvata perinteistä maataloutta.
– Jos globaalisti vähennettäisiin lihansyöntiä, niin silloin Solar Foodsin kaltaisia ratkaisuja ei välttämättä tarvittaisi ollenkaan. Mutta koska maailma ei näytä menevän siihen suuntaan, ovat vaihtoehdot tarpeen.
SOLAR FOODS
Pitkänen on itse kotoisin maitotilalta Pohjois-Savosta.
– Nykyisen ruoantuotannon pitäisi mennä kestävämpään suuntaan. Moninaista ruoantuotantoa tarvitaan, ennen kaikkea Suomessa, missä kasvuolosuhteet ovat haastavat ruoan tuotannolle.
Soleini-nimestä voi jollekin tulla mieleen 1970-luvun tieteisleffa ja -kirja Soylent Green. Vertauksen dystooppiseen tarinaan Pitkänen torjuu jyrkästi.
– Tiedän leffan, mutta nimellä ei viitata siihen. Eikä meillä ole tässä mitään ajatusyhteyttä dystopiaan tai maailmanloppuun. Mutta ajatus ruuan omavaraisuudesta Suomessa on meillä tässä kyllä mukana, tieteellinen johtaja myöntää.
Jos soleini on elintarvikkeiden raaka-aine, niin miltä se sitten maistuu?
– Meidän kokki on sanonut, että se nostaa esiin muiden raaka-aineiden makuja. Sen omassa maussa on jotain sienimäistä, pähkinämäistä ja vähän jotain porkkanaa, koska siinä on karotenoideja, luettelee Pitkänen.
Soleinia ei ole tarkoitettu sellaisenaan nautittavaksi – se on raaka-aine, joka sekoitetaan muihin raaka-aineisiin. Singaporessa sitä lisätään vegaaniseen jäätelöön, jossa se antaa täyteläistä suutuntumaa ja estää jäätelön liian nopeaa sulamista. SOLAR FOODS
Solar Foods visioi, että soleinia voisi löytyä tulevaisuudessa pastasta tai proteiinijuomasta. Kaupallisen menestyksen kuitenkin ratkaisee se, onnistutaanko soleini yhdistämään hyvin muihin raaka-aineisiin ja pystytäänkö siitä tekemään kuluttajille maistuvia ja heidän haluamiaan tuotteita.
– Onhan tässä riskinsä, ja riski voi realisoitua. Että tästä ei tulekaan mitään. Mutta meillä on halu ja velvollisuus on yrittää, toteaa Pitkänen.